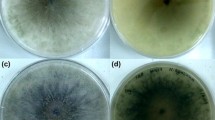

Abstract
Trichophyton rubrum, an anthropophilic dermatophyte fungus, is the predominant causative agent of superficial skin infections in human population. There are only scanty reports on drug susceptibility profiling of T. rubrum. Neither mechanisms for drug resistance development nor correlation between in vitro drug susceptibility and in vivo response to treatment is known for that species. In this study, changes in the in vitro susceptibilities to fluconazole (FLZ) and itraconazole (ITZ) among thirty T. rubrum clinical strains subjected to sequential passages in the presence or absence of the azoles were investigated. Each strain was passaged 12 times at 4-week intervals as three parallel cultures, maintained on a drug-free medium (1), and a medium containing FLZ (2) or ITZ (3) at subinhibitory concentrations. Susceptibility to FLZ and ITZ of the original strain and its 3 subcultures was determined by microdilution method. The MIC values of the two azoles remained unaltered for all T. rubrum strains tested, after 12 passages on a drug-free medium. Among the strains grown with FLZ, an increase in the MICs of FLZ and ITZ was noted in 17 (56.7 %) and 19 (63.3 %) strains, respectively. Increased MICs of ITZ and FLZ were demonstrated for 24 (80 %) and 20 (66.7 %) strains that were propagated with ITZ. The results indicate the capacity of T. rubrum to develop resistance toward the azoles after prolonged exposure to these drugs. Resistance of T. rubrum to azoles plays an important role in therapy failures and consequently contributes to persistence and chronicity of the infections.
Similar content being viewed by others
Avoid common mistakes on your manuscript.
Introduction
Dermatomycoses are the most prevalent forms of fungal disease in humans worldwide [1, 2]. Different dermatophyte species are the agents, and those that are anthropophilic in their natural habitat, with Trichophyton rubrum in particular, account for the bulk of superficial dermatomycoses, such as tinea pedis (athlete’s foot) and tinea unguium (onychomycosis). The predominance of the anthropophilic species in the etiology of superficial fungal infections is a reflection of increased population mobility, through migration and tourism, as well as the diversity of social activities and habits (e.g., widespread use of public recreational facilities, such as swimming pools and health clubs).
Athlete’s foot and onychomycosis are the two most common dermatomycoses. The prevalence of both these conditions ranges from 3 to 23 % in general population [3]. In high-risk groups (swimmers, runners, wrestlers, soldiers, mine workers, etc.), it is even greater, sometimes exceeding 60 % [4–6]. Fungal infections may assume a serious and complicated clinical picture, often being accompanied by secondary bacterial infections and/or other skin disorders that strongly influence the course and severity of tinea disease. Furthermore, certain conditions like onychomycosis require prolonged treatment with a combination of drugs, and their activities are usually empirically determined. Adverse drug reactions and drug allergies are not uncommon [7]. Overall, the burden of the tinea infections exerts a profoundly negative effect on the patient’s quality of life [8–10].
In vitro antimycotic susceptibility testing provides clinicians with a reliable means of forecasting or verifying the clinical effectiveness of the therapeutic regimens. However, evaluation of the antifungal susceptibilities of dermatophytes is still an out-of-routine clinical practice. A major reason for this is a lack of a standardized reference method for testing filamentous fungi. This has importantly hampered research into the mechanisms of drug resistance in the dermatophytes. Unlike for bacteria and yeasts [11, 12], no experimental studies on the stability of drug susceptibility patterns have been performed for the dermatophytes.
The purpose of this study was to investigate possible alterations in azole susceptibilities among 30 clinical isolates of T. rubrum after exposure to drug pressure in vitro.
Materials and Methods
Thirty isolates of T. rubrum were included in the study. The isolates were recovered from 29 patients suffering from either onychomycosis (26; one patient was diagnosed as having also tinea cruris) or tinea pedis (3), treated in the Department of Dermatology, Venereology and Allergology of Wrocław Medical University, in the years 2006–2007. The strains used in this study had previously been genotyped by means of randomly amplified polymorphic DNA (RAPD) analysis and tandemly repetitive subelements (TRS)-PCR analysis, for which the results were published elsewhere [13].
The strains T. rubrum DSM 4167 (Deutsche Sammlung von Mikroorganismen und Zellkulturen (DSMZ), Braunschweig, Germany), Pichia kudriavzevii (teleomorph of Candida krusei) DBVPG 7235, and Candida parapsilosis (DBVPG 6150) from the Industrial Yeasts Collection DBVPG (Perugia, Italy) were used as quality controls.
The species-level identification was performed by using both conventional and molecular methods, essentially as described elsewhere [13].
In vitro susceptibility testing was performed using a modified CLSI microdilution method (M38-A) in 96-well flat-bottomed microdilution plates [11, 14, 15]. Two antifungal agents were used—fluconazole (FLZ; Polfarmex, Poland) and itraconazole (ITZ; Polpharma, Poland). Fluconazole was dissolved in distilled water, whereas itraconazole was dissolved in 100 % dimethyl sulfoxide (DMSO; Sigma-Aldrich, Germany). Both drugs were prepared as stock solutions at a concentration of 1 mg/mL and serially diluted in accordance with the CLSI M38-A standard procedure. The final concentrations assayed ranged from 0.125 to 64.0 μg/mL for FLZ and from 0.06 to 16.0 μg/mL for ITZ.
For the inocula preparation, cultures of T. rubrum were grown on potato dextrose agar (PDA; Becton–Dickinson, Franklin Lakes, USA; 4 g potato starch, 20 g dextrose, and 15 g agar per liter) slants at 28 °C for 7 days to induce conidia production. The fungal colonies were covered with 5 mL of sterile saline (0.9 %), and the cultures were gently swabbed with a sterile loop to dislodge the conidia from the hyphal mat. The resulting suspension was transferred into a sterile tube and allowed to settle for 15 min to retain mainly microconidia, which were counted on a hemocytometer. The conidial suspensions were diluted to a final concentration of ca. 0.5–5.0 × 104 CFU/mL desired in RPMI 1640 medium (Gibco, New York, USA) without sodium bicarbonate, supplemented with 2 % (w/v) glucose, buffered to pH 7.0 with 0.165 M morpholinepropanesulfonic acid (MOPS). The microdilution plates were set up following the CLSI M38-A protocol. Column 1 was filled with 200 μL of medium to serve as a sterility control. Columns 2–11 were filled with 100 μL of the inoculum and the same volume of serially diluted antifungal agent. Column 12 was filled with 200 μL of the inoculum and served as a growth control. The microdilution plates were incubated at 28 °C and were read visually after 7 days of incubation. The MIC was defined as the point at which the organism was inhibited in 90 % compared with the growth in the control well. The results were read independently by two observers, with the aid of a high-quality magnifying glass and under a good light source.
To assess the potential variability in susceptibility of T. rubrum to azole antifungals, three populations of the fungus were established from a single colony of each T. rubrum strain under the study; the first two populations were propagated on Sabouraud dextrose agar (SDA with chloramphenicol and cycloheximide; BIOCORP, Warsaw, Poland; 40 g glucose, 10 g peptone, 15 g agar, 0.05 g chloramphenicol, and 0.4 g cycloheximide per liter) plates supplemented with either FLZ or ITZ at a concentration of 1 μg/mL and 0.125 μg/mL, respectively, and the third one was propagated on drug-free SDA medium. The plates were incubated at 25 °C under weak light exposure. The drug concentrations were chosen since they were the highest concentrations not inhibiting the growth of all T. rubrum strains under the study subjected to serial passage on SDA with incremental concentrations of each drug (i.e., 0.125–32 μg/mL for FLZ and 0.06–8 μg/mL for ITZ). The three parallel cultures of each T. rubrum strain were passaged 12 times at 4-week intervals, and after that time, susceptibility testing against FLZ and ITZ was performed for each of the three cultures, as described above.
When preparing the inocula of the strains grown with FLZ or ITZ, the PDA slants also contained the drugs at respective concentrations (i.e., 1 μg/mL for FLZ and 0.125 μg/mL for ITZ).
The methodological strategy used for drug susceptibility determination was schematically depicted in Fig. 1.
To calculate the geometric means of the MICs, the MIC values exceeding the ranges tested were approximated to the highest values within the ranges (i.e., MICs of >16, and >64 μg/mL were approximated to 16, and 64 μg/mL, respectively). The differences in the MIC values of FLZ and ITZ between T. rubrum strains of three populations (i.e., grown with FLZ, ITZ, and without drug) were compared by the Wilcoxon signed-rank test. Statistical significance was set at P < 0.05 level. All calculations were done using the STATISTICA software package (ver. 8.0; StatSoft Inc., Tulsa, USA).
Results
The results of MIC testing for the isolates studied are presented in Table 1. The first determination of MICs for FLZ and ITZ was performed shortly before the passage experiment. The MIC values of FLZ ranged between 2 and >64 μg/mL (mean MIC value 14.1 μg/mL), while those of ITZ were within the range of 0.25–4 μg/mL (mean MIC value 1.8). The MIC values of the two azoles remained unaltered for all T. rubrum strains tested, after 12 passages on a drug-free medium. However, most of the T. rubrum strains showed significant changes in their MIC values of FLZ and ITZ, when propagated on drug-containing media. The MIC ranges were of 4–>64 μg/mL for FLZ and 0.5–>16 μg/mL for ITZ.
Among the strains grown with FLZ, half of them doubled their MICs of that drug, whereas 12 (40 %) strains preserved their FLZ MICs from before passage. For 2 strains, a fourfold increase in the MIC value of FLZ was observed. For one strain, the MIC value of FLZ dropped from 8 to 4 μg/mL. At the same time, 11 (36.7 %) of the strains grown with FLZ had their ITZ MIC values unchanged when compared to those from before passage; 19 (63.3 %) strains, however, achieved an increase in MIC values of ITZ. This increase was twofold for 11 strains, fourfold for 4 strains, eightfold for 3 strains, and 64-fold for one strain.
As for the strains propagated with ITZ, 6 (20 %) strains had their MIC values of that drug as determined prior to passaging. For the remaining 24 (80 %) strains, an increase in the MIC value of ITZ was noted. This increase was 2-, 4-, 8-, 16-, and 64-fold for 13, 6, 3, 1, and 1 strains, respectively. The MIC values of FLZ for the strains grown with ITZ were the same as from before passaging for 10 (33.3 %) strains and elevated twofold or fourfold for 16 and 4 strains, correspondingly.
The increase in MIC of one azole was accompanied by an increase in MIC of the second azole in case of 13 (43.3 %) strains grown with FLZ and 18 (60 %) strains grown with ITZ. For 11 (36.7 %) strains cultured with FLZ, and 8 (26.7 %) strains cultured with ITZ, the MICs of the two azoles differed in that the MICs of one drug remained unaltered, whereas those of another were increased with reference to the values obtained for pre-passaged (original) strains.
Comparison of the azole MICs between two populations, grown with ITZ and FLZ, revealed that the MIC values of ITZ were higher if the strains were grown with that drug in 13 (43.3 %) cases and only in 4 cases, when the strains were grown with FLZ. In the remaining 13 cases, the ITZ MICs were the same in both populations. The MIC values of ITZ against T. rubrum strains grown with that drug were statistically higher than those against T. rubrum strains grown with FLZ (P = 0.02).
The MIC values of FLZ were identical for strains grown with FLZ and ITZ in 21 (70 %) cases. Out of 9 remaining cases, in 7, the MICs of FLZ were higher for strains grown with ITZ than those for strains grown with FLZ. The mean MIC values of FLZ for T. rubrum strains passaged with FLZ and ITZ were 19.3 and 21 μg/mL, respectively.
Discussion
There are relatively scanty reports on drug susceptibility profiling of T. rubrum, and the main reason for this is the lack of a standardized method to test the antifungal susceptibilities of dermatophyte fungi [16–18]. Studies on the development of drug resistance in dermatophytes or correlation between in vitro and in vivo activities of antimycotic agents against dermatophyte species are even more scarce. In this paper, stability of susceptibilities to FLZ and ITZ among T. rubrum clinical isolates subjected to sequential passage in the presence or absence of the azoles was investigated. To the authors’ knowledge, the experiment conducted within this study is the first of this type with dermatophytes. Apart from a single study of Osborne et al., who investigated the acquired resistance to terbinafine in T. rubrum strains grown with that drug [18], similar studies have only been performed with non-dermatophyte species, mainly those of Candida and Aspergillus genus. For instance, Barchiesi et al. [19] reported on the development of resistance to FLZ in a drug-susceptible strain of Candida tropicalis after sequential passages on increasing concentrations of FLZ. Likewise, FLZ-resistant Candida albicans strains were generated by passaging susceptible strains in the presence of FLZ [11, 20]. Seo et al. [21] demonstrated the generation of polyene-resistant mutants by repeated passaging of Aspergillus flavus on graded concentrations of amphotericin B, whereas Manavathu et al. [22] showed reduced susceptibility to ITZ, miconazole (MNZ), and ketoconazole (KTZ) in a strain of Aspergillus fumigatus grown from conidia of a susceptible clinical isolate on a medium containing MNZ.
The key finding of the study was that sequential passage of T. rubrum clinical isolates in the presence of FLZ or ITZ resulted in an increase in the MICs of both drugs for the majority of isolates. This clearly indicates the ability of T. rubrum to develop acquired resistance toward the azoles after prolonged exposure to subinhibitory concentrations of those drugs. That this in vitro observation has its reflection in vivo is supported by the observation of the increased MIC values for the azole agents, including ITZ and KTZ in T. rubrum strains obtained from onychomycosis patients after treatment with either KTZ or a combination of ITZ and terbinafine [14, 23]. Another finding from this study was increased MIC values for FLZ among the strains grown with ITZ, and, conversely, the increased MICs for ITZ among the strain grown with FLZ. This confirms the cross-resistance patterns of these two azoles, since they share a common cellular target and mode of action. (The azoles act through inhibiting lanosterol-14α-demethylase, a key enzyme involved in the biosynthesis of ergosterol, a major component of the fungal cell membrane) [24].
Finally, the MIC values for ITZ were significantly lower, compared to those for FLZ. This is in line with the results of other researchers [14, 17, 25] and confirms a high propensity of T. rubrum to develop resistance toward FLZ.
The mechanisms that underlie resistance of T. rubrum, and other dermatophyte species, to azole derivatives are very poorly understood. One proposed mechanism to account for azole resistance in T. rubrum is drug efflux by ATP-binding cassette (ABC) transporters. The T. rubrum TruMDR1 and TruMDR2 genes, encoding for those transporters (efflux pumps), were demonstrated to be overexpressed by the fungus in the presence of various antifungal drugs, including azoles [24]. Another mechanism that may be involved in resistance of T. rubrum to azole compounds relates to the up-regulation of the lanosterol-14α-demethylase, the molecular target for the azoles. The overexpression of the ERG11 gene, encoding for this enzyme, was evidenced in T. rubrum after exposure to subinhibitory concentrations of KTZ [24]. Of further interest is whether acquisition of azole resistance results from drug pressure that induces transcription of resistance genes in the entire fungal population or from selection, in the presence of the drug, for a resistant subset of population, a phenomenon referred to as heteroresistance. The pattern of heterogeneous resistance to azoles was documented in Candida albicans [26] and Cryptococcus neoformans [27]. In both these species, the resistance was transient since, after cessation of drug pressure, the yeasts switched to drug-susceptible phenotype. The purpose of this study was only to demonstrate changes in susceptibilities of T. rubrum strains to azoles over serial passage in the presence of the drugs, and not to disclose the mechanisms behind these changes. However, another study, which is now in progress, aims to determine whether a decrease in azole susceptibility observed here is transient and lost after serial growth in the absence of drug.
It has to be mentioned that drug pressure may not only induce changes in drug susceptibility phenotype but also promote alterations at the genotype level. Hryncewicz-Gwóźdź et al. [28] demonstrated a change within a tandemly repetitive element (TRS) locus between two isogenic T. rubrum isolates, after serial passage in vitro with and without drug.
To conclude, the observation from this study is that T. rubrum can easily develop resistance to azole antifungals after being subjected to subinhibitory concentrations of the drugs and it has important implications for the clinical management of T. rubrum infections. Resistance of the fungus to azoles, which are still at the forefront of treatment for dermatophytoses, is vastly responsible for therapy failures and consequently contributes to persistence and chronicity of the infections.
References
Aly R. Ecology and epidemiology of dermatophyte infections. J Am Acad Dermatol. 1994;31(Suppl 2):21–5.
Tietz HJ, Kunzelmann V, Schönian G. Changes in the fungal spectrum of dermatomycoses. Mycoses. 1995;38:33–9.
Burzykowski T, Molenberghs G, Abeck D, et al. High prevalence of foot diseases in Europe: results of the Achilles Project. Mycoses. 2003;46:496–505.
Lacroix C, Baspeyras M, de La Salmonière P, et al. Tinea pedis in European marathon runners. J Eur Acad Dermatol Venereol. 2002;16:139–42.
Gentles JC, Holmes JG. Foot ringworm in coal-miners. Br J Ind Med. 1957;3:22–9.
Noguchi H, Hiruma M, Kawada A, Ishibashi A, Kono S. Tinea pedis in members of the Japanese Self-defence Forces: relationships of its prevalence and its severity with length of military service and width of interdigital spaces. Mycoses. 1995;38:494–9.
Ghannoum MA, Rice LB. Antifungal agents: mode of action, mechanisms of resistance, and correlation of these mechanisms with bacterial resistance. Clin Microbiol Rev. 1999;12:501–17.
Szepietowski JC, Reich A. Stigmatisation in onychomycosis patients: a population-based study. Mycoses. 2009;52:343–9.
Drake LA, Patrick DL, Fleckman P, et al. The impact of onychomycosis on quality of life: development of an international onychomycosis-specific questionnaire to measure patient quality of life. J Am Acad Dermatol. 1999;41:189–96.
Elewski BE. The effect of toenail onychomycosis on patient quality of life. Int J Dermatol. 1997;36:754–6.
Cowen LE, Sanglard D, Calabrese D, Sirjusingh C, Anderson JB, Kohn LM. Evolution of drug resistance in experimental populations of Candida albicans. J Bacteriol. 2000;182:1515–22.
Arikan S. Current status of antifungal susceptibility testing methods. Med Mycol. 2007;45:569–87.
Hryncewicz-Gwóźdź A, Jagielski T, Sadakierska-Chudy A, Dyląg M, Pawlik K, Baran E, et al. Molecular typing of Trichophyton rubrum clinical isolates from Poland. Mycoses. 2011;54:726–36.
Santos AD, de Carvalho Araújo RA, Santos AD, Kohler LM. Molecular typing and antifungal susceptibility of Trichophyton rubrum isolates from patients with onychomycosis pre- and post-treatment. Int J Antimicrob Agents. 2007;29:563–9.
Fachin AL, Maffei CM, Martinez-Rossi NM. In vitro susceptibility of Trichophyton rubrum isolates to griseofulvin and tioconazole. Induction and isolation of a resistant mutant to both antimycotic drugs. Mutant of Trichophyton rubrum resistant to griseofulvin and tioconazole. Mycopathologia. 1996;135:141–3.
Ghannoum MA, Arthington-Skaggs B, Chaturvedi V, et al. Interlaboratory study of quality control isolates for a broth microdilution method (modified CLSI M38-A) for testing susceptibilities of dermatophytes to antifungals. J Clin Microbiol. 2006;44:4353–6.
Barros da Silva ME, de Assis Santos D, Hamdan JS. Evaluation of susceptibility of Trichophyton mentagrophytes and Trichophyton rubrum clinical isolates to antifungal drugs using a modified CLSI microdilution method (M38-A). J Med Microbiol. 2007;56:514–8.
Osborne CS, Hofbauer B, Favre B, Ryder NS. In vitro analysis of the ability of Trichophyton rubrum to become resistant to terbinafine. Antimicrob Agents Chemother. 2003;47:3634–6.
Barchiesi F, Calabrese D, Sanglard D, et al. Experimental induction of fluconazole resistance in Candida tropicalis ATCC 750. Antimicrob Agents Chemother. 2000;44:1578–84.
Marr KA, Lyons CN, Ha K, Rustad TR, White TC. Inducible azole resistance associated with a heterogeneous phenotype in Candida albicans. Antimicrob Agents Chemother. 2001;45:52–9.
Seo K, Akiyoshi H, Ohnishi Y. Alteration of cell wall composition leads to amphotericin B resistance in Aspergillus flavus. Microbiol Immunol. 1999;43:1017–25.
Manavathu EK, Vazquez JA, Chandrasekar PH. Reduced susceptibility in laboratory-selected mutants of Aspergillus fumigatus to itraconazole due to decreased intracellular accumulation of the antifungal agent. Int J Antimicrob Agents. 1999;12:213–9.
Gupta AK, Kohli Y. Evaluation of in vitro resistance in patients with onychomycosis who fail antifungal therapy. Dermatology. 2003;207:375–80.
Martinez-Rossi NM, Peres NTA, Rossi A. Antifungal resistance mechanisms in dermatophytes. Mycopathologia. 2008;166:369–83.
Fernández-Torres B, Carrillo AJ, Martìn E, et al. In vitro activities of 10 antifungal drugs against 508 dermatophyte strains. Antimicrob Agents Chemother. 2001;45:2524–8.
Marr KA, Lyons CN, Ha K, Rustad TR, White TC. Inducible azole resistance associated with a heterogeneous phenotype in Candida albicans. Antimicrob Agents Chemother. 2001;45:52–9.
Yamazumi T, Pfaller MA, Messer SA, et al. Characterization of heteroresistance to fluconazole among clinical isolates of Cryptococcus neoformans. J Clin Microbiol. 2003;41:267–72.
Hryncewicz-Gwóźdź A, Jagielski T, Kalinowska K, Baczynska D, Plomer-Niezgoda E, Bielecki J. Stability of tandemly repetitive subelement PCR patterns in Trichophyton rubrum over serial passaging and with respect to drug pressure. Mycopathologia. 2012;174:383–8.
Author information
Authors and Affiliations
Corresponding author
Rights and permissions
About this article
Cite this article
Hryncewicz-Gwóźdź, A., Kalinowska, K., Plomer-Niezgoda, E. et al. Increase in Resistance to Fluconazole and Itraconazole in Trichophyton rubrum Clinical Isolates by Sequential Passages In Vitro under Drug Pressure. Mycopathologia 176, 49–55 (2013). https://doi.org/10.1007/s11046-013-9655-y
Received:
Accepted:
Published:
Issue Date:
DOI: https://doi.org/10.1007/s11046-013-9655-y